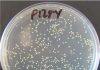
MRSA enzyme could help tackle antibiotic tolerance timebomb

The University of Exeter has been awarded £5 million for a project that aims to instil researchers with improved awareness of the benefits of collaborating with business.


The new business and entrepreneurial skills scheme will provide support for postgraduate and early career researchers seeking to improve their awareness of the advantages of, as well as opportunities for, deeper collaboration with businesses.
Funded by Research England, part of UK Research and Innovation, through its Research England Development (RED) fund, the scheme aims to increase the movement of researchers between universities and businesses, and improve employability routes and participation in business research and development.
It will be taken forward by a partnership of universities, led by Exeter, with support from the Chartered Association of Business Schools (Chartered ABS).
A project team based at the University of Exeter Business School will work with business schools across the UK to create an innovative programme of support for researchers that will allow them to develop the skills, competencies and mindsets necessary to identify business opportunities and engage more effectively with external organisations.
Professor Alison Truelove, Project Lead and Director of the Centre for Innovation in Business Education at the University of Exeter Business School, said: “This diverse and innovative project will help researchers to enhance their awareness of the value of their skills and knowledge to industry. It will also help them to become better equipped at recognising opportunities for collaboration, ensuring their expertise has a wider impact beyond the confines of universities.”
Professor Lisa Roberts, Vice Chancellor of the University of Exeter, said: “We are delighted to be leading this important and exciting programme that will boost the business, management and entrepreneurial skills of researchers so that they can fully embrace the economic, social, environmental and commercial benefits of their work through collaborating with businesses and industry.
“The University of Exeter is committed to working ever more closely with business by allowing access to our capabilities, expertise and skills so that we can together overcome the challenges of the 21st century, creating a sustainable, healthy and socially just future for all.”
Professor Alexandra Gerbasi, Dean of the University of Exeter Business School and Deputy Pro Vice Chancellor added: “This project is an excellent example of the innovative nature of the University of Exeter Business School and our determination to tackle future challenges and opportunities through strong partnerships and collaboration.”
The Chartered ABS will support the partnership of UK business schools developing the project, but the aim is to engage an even wider range of universities, business schools and other partners over time. So far the Chartered ABS has built relationships with university partners, business partners such as GSK, Babcock and the Pennon Group, and organisations including the National Centre for Universities and Business (NCUB), the British Academy of Management (BAM) and ScaleUp Institute.
Professor Robert MacIntosh, Chair of the Chartered Association of Business Schools and Pro-Vice-Chancellor at Northumbria University, said:“Business schools have deep expertise in innovation and bringing products and services to market. They also excel in executive training and development. We are therefore delighted at this opportunity to collaborate across a range of academic disciplines and with industry to equip academics with business skills. It showcases the real value that business schools can add to their parent universities and to the wider economy.”
David Sweeney CBE, Executive Chair of Research England, said: “This project addresses the R&D people and culture strategy commitment to more flexible, cross-sector training programmes to encourage more movement and collaboration between academia and industry.
“It will help us make the best use of our talented researchers and innovators to increase R&D activity, economic growth and productivity.
“Research England is grateful to the Chartered Association of Business Schools for bringing together an exciting partnership of universities, business schools and businesses to develop and deliver it.”
The scheme will include four workstreams:
- Research into what already exists in this space, what is effective and where the gaps are.
- Development of a programme of activity that supports postgraduate researchers/ECRs to build the competencies and mindsets necessary for effective cross-fertilisation of university-based research with industry-based activities.
- Multi-disciplinary networking opportunities for postgraduate and early career researchers interested in engaging with industry.
- A campaign to champion the advantages of enhanced collaboration between academia and industry, specifically focusing on postgraduate and early career researchers and businesses who have yet to embrace the potential for collaboration with those in HEIs.
The project is due to start in January 2023 and will run until January 2027.